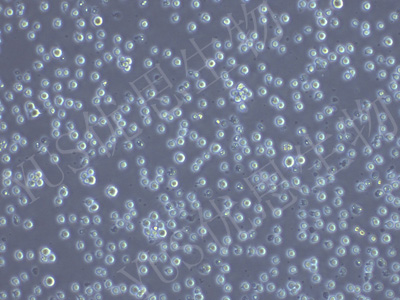

产品中心
产品中心
-

RAW 264.7-EGFP 小鼠单核巨噬细胞白血病细胞(绿色荧光标记)(STR鉴定)
货号:YLM120规格: 1*10^6 -
C1498-LUC 小鼠白血病细胞(荧光素酶标记)(种属鉴定)
货号:YLM125规格: 1*10^6 -

4T1-GFP 小鼠乳腺癌细胞(绿色荧光标记)(STR鉴定)
货号:YLM126规格: 1*10^6 -

NIH/3T3-GFP 小鼠胚胎细胞(绿色荧光标记)(STR鉴定)
货号:YLM130规格: 1*10^6 -

B16-F10-GFP 小鼠皮肤黑色素瘤细胞(绿色荧光标记)(STR鉴定)
货号:YLM131规格: 1*10^6 -

Panc02-GFP 小鼠胰腺癌细胞(绿色荧光标记)(STR鉴定)
货号:YLM132规格: 1*10^6 -

BV2-EGFP 小鼠小胶质细胞(绿色荧光标记)(STR鉴定)
货号:YLM138规格: 1*10^6 -

HePa1-6-GFP 小鼠肝癌细胞(绿色荧光标记)(STR鉴定)
货号:YLM139规格: 1*10^6 -

RM-1-GFP 小鼠前列腺癌细胞(绿色荧光标记)(STR鉴定)
货号:YLM149规格: 1*10^6 -

CT26.WT-GFP 小鼠结肠癌细胞(绿色荧光标记)(STR鉴定)
货号:YLM150规格: 1*10^6 -

MC38-GFP 小鼠结肠癌细胞(绿色荧光标记)(STR鉴定)
货号:YLM151规格: 1*10^6
在线咨询
Online consultation

关注微信公众号


